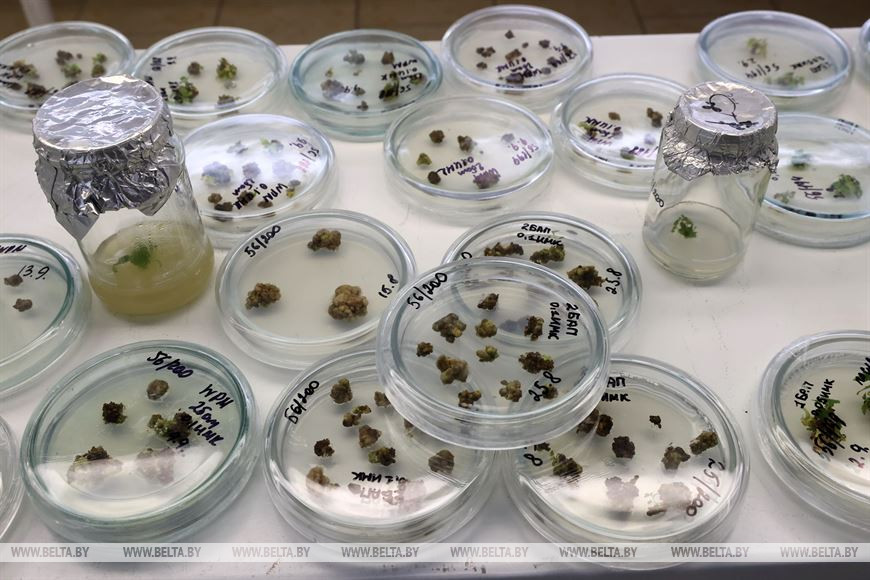

29 сентября, Гомель /Корр. БЕЛТА/. Ученые Института леса Национальной академии наук активно занялись микроклонированием растений. Таким научным подходом быстрого и качественного размножения деревьев занимались и раньше, но теперь биотехнология вышла на промышленный уровень. В теплицах лесопитомника экспериментальной лесной базы НИИ леса выращивается более 12 тыс. саженцев осины и березы, возраст которых 9 месяцев. Столько же находится в пробирках лаборатории научно- исследовательского отдела генетики, селекции и биотехнологий НИИ леса.-0-

Фото Сергея Холодилина
- размещаются материалы рекламно-информационного характера.